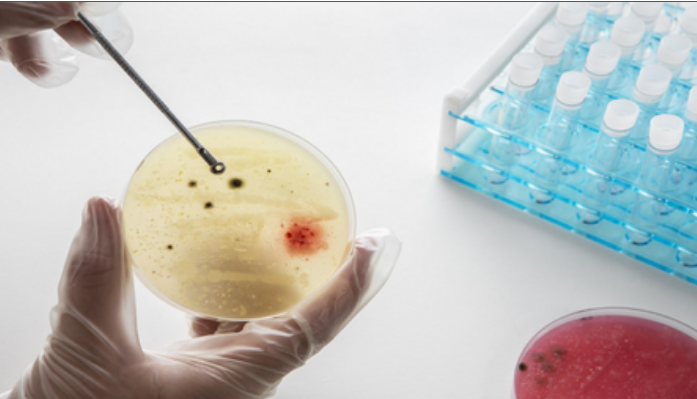

स्टेरॉइड्स से टीबी का इलाज हो सकता है और प्रभावी, नई स्टडी में मिला सबूत
दुनियाभर में हर साल 1 करोड़ से ज्यादा लोग ट्यूबरक्लोसिस (टीबी) से प्रभावित होते हैं। इस बीच एक नई वैज्ञानिक स्टडी में सामने आया है कि स्टेरॉइड्स का इस्तेमाल टीबी के इलाज में सहायक हो सकता है। साइंटिफिक रिपोर्ट्स पत्रिका में प्रकाशित अध्ययन से पता चला है कि स्टेरॉइड्स, खासतौर पर डेक्सामेथासोन नाम की दवा, टीबी से लड़ने में एक उपयोगी पूरक इलाज साबित हो सकती है। टीबी एक संक्रामक बीमारी है जो मुख्य रूप से फेफड़ों पर असर डालती है।

अब तक इसका इलाज मुख्य रूप से एंटीबायोटिक से किया जाता रहा है। हालांकि, कई मामलों में शरीर की इम्यून प्रतिक्रिया इतनी तेज होती है कि यह खुद ही शरीर के ऊतकों को नुकसान पहुंचाने लगती है। इस स्थिति को अत्यधिक इंफ्लेमेटरी कहा जाता है। स्टेरॉइड्स का उपयोग इसी इंफ्लामेशन को कम करने के लिए किया जाता है, लेकिन अब यह सामने आया है कि ये दवाएं सिर्फ सूजन को ही नहीं कम करती, बल्कि शरीर की प्रतिरक्षा प्रणाली को बैक्टीरिया से लड़ने में भी मदद कर सकती हैं। स्टडी में विशेष रूप से मैक्रोफेज नाम की प्रतिरक्षा कोशिकाओं पर ध्यान दिया गया।
ये कोशिकाएं शरीर में बैक्टीरिया और अन्य हानिकारक चीजों को पहचानकर उन्हें खत्म करती हैं। वैज्ञानिकों ने खून और फेफड़ों के फ्लूइड से लिए गए मैक्रोफेज को टीबी के बैक्टीरिया से संक्रमित किया और फिर डेक्सामेथासोन से उनका इलाज किया। इस प्रक्रिया के दौरान पाया गया कि जब इन कोशिकाओं को स्टेरॉइड्स से ट्रीट किया गया, तो उनकी बैक्टीरिया को मारने की क्षमता बढ़ गई। डेक्सामेथासोन दवा मैक्रोफेज के अंदर एक प्रक्रिया को सक्रिय करती है जिसे ऑटोफैगी कहा जाता है।
इस प्रक्रिया में कोशिका खुद ही अपने अंदर के संक्रमित हिस्सों को साफ करती है। इसके अलावा, एक और प्रक्रिया, फेगोसोमल एसिडिफिकेशन, के जरिए यह दवा कोशिकाओं को अंदर से एसिडिक माहौल बनाकर बैक्टीरिया को खत्म करने में सक्षम बनाती है। डबलिन के ट्रिनिटी कॉलेज के प्रोफेसर ऑफ मेडिसिन जोसेफ कीन ने कहा, ''टीबी के इलाज में स्टेरॉइड्स का उपयोग अक्सर कम होता है, जबकि ये बहुत असरदार साबित हो सकते हैं, खासकर गंभीर मामलों में जैसे कि टीबी मैनिंजाइटिस (जो दिमाग को प्रभावित करता है)। यह अध्ययन बताता है कि स्टेरॉइड्स न केवल सूजन को नियंत्रित करते हैं, बल्कि शरीर की रोग प्रतिरोधक क्षमता को भी मजबूत बनाते हैं।''